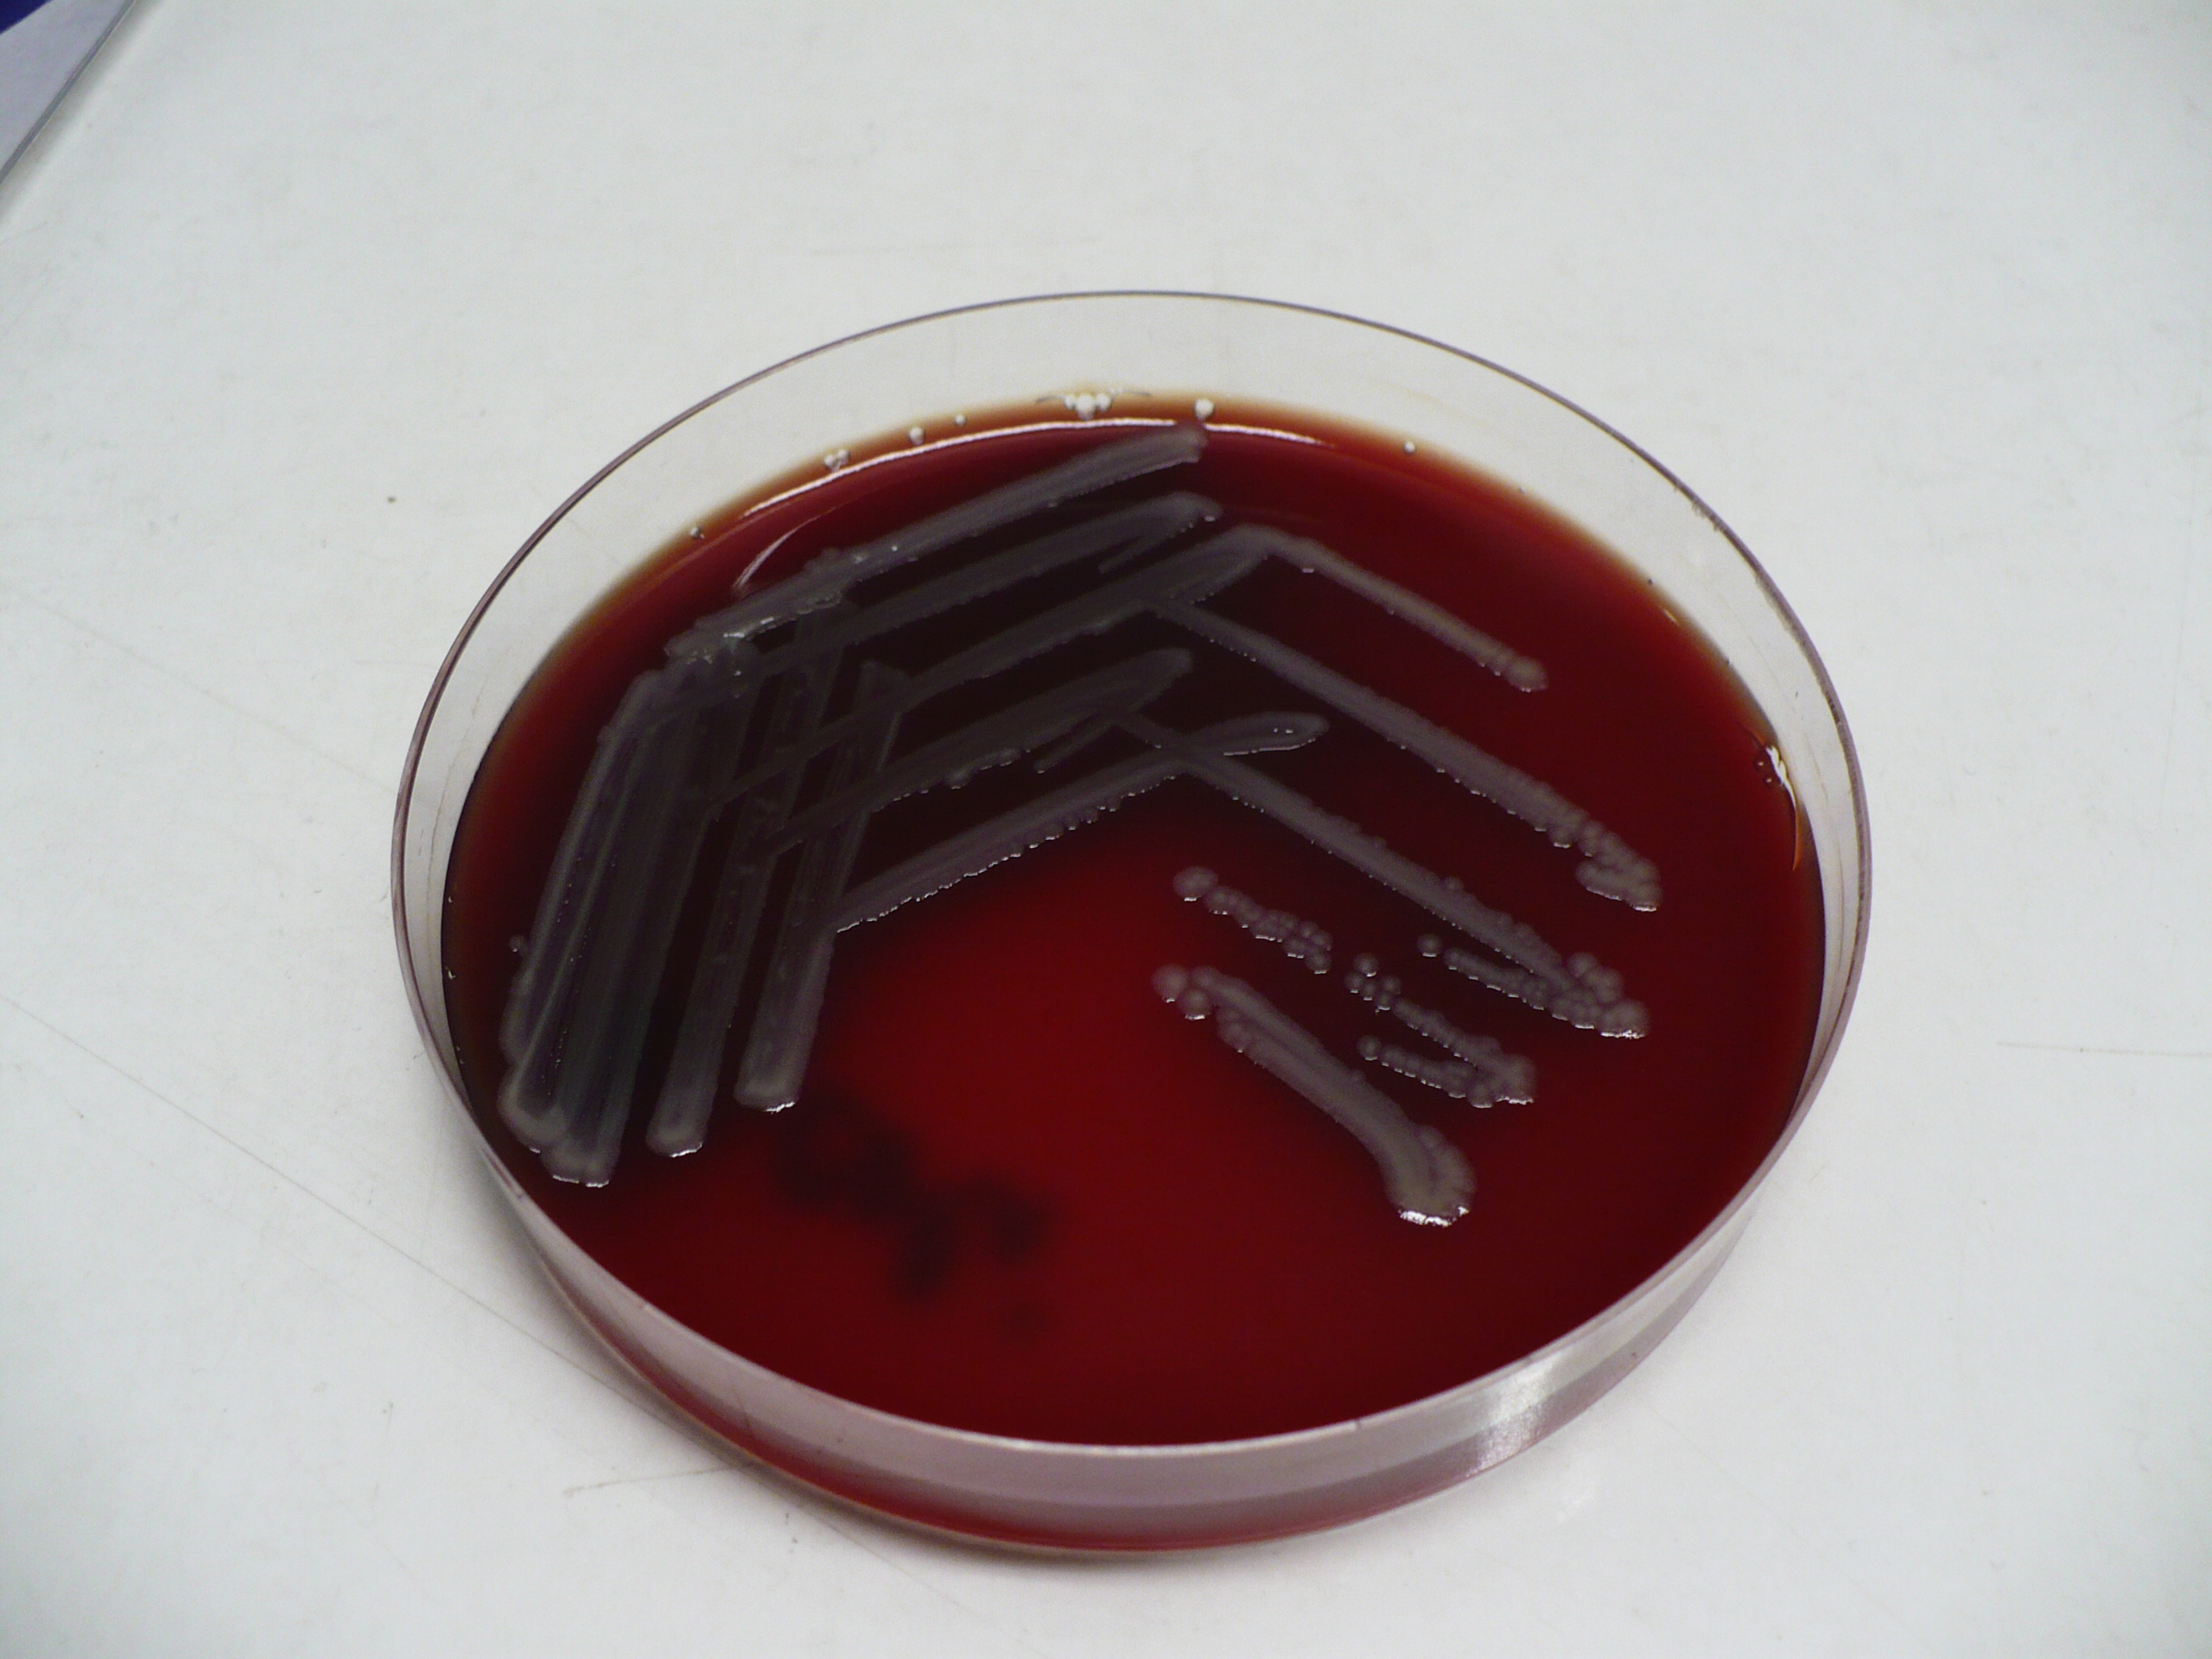
Escherichia coli na krevním agaru

Escherichia coli
| Escherichia coli | |
| Enterobacteriacae | |
| Escherichia | |
Escherichia coli na krevním agaru | |
| Morfologie | G− tyčinka |
|---|---|
| Vztah ke kyslíku | fakultativně anaerobní |
| Kultivace | krevní agar, MacConkey, Endův agar |
| Antigeny | K (polysacharidový kapsulární), H (bílkovinný bičíkový), O (lipopolysacharidový tělový) |
| Faktory virulence | pouzdro, toxiny, pili |
| Zdroj | člověk (endogenní i exogenní infekce), zvíře |
| Přenos | fekálně-orální, alimentární (kontaminovaná potrava, voda) |
| Onemocnění | viz infekce vyvolané E. coli |
| Diagnostika | kultivace, sérotypizace |
| Terapie | komunitní kmeny citlivé k běžným ATB, nitrofurantoin, cotrimoxazol, ampicilin, fluorochinolony, aminoglykosidy, viz terapie průjmových onemocnění |
| MeSH ID | D004926 |
Escherichia coli se nachází u převážné většiny teplokrevných živočichů. Tvoří součást fyziologické mikroflóry tlustého střeva a distální části ilea. Jedinec je kolonizován takřka okamžitě po narození, nejčastěji alimentární cestou nebo přenosem od již osídleného jedince. Dlouhodobě není E. coli schopna existovat mimo hostitele. Proto její nález (např. v pitné vodě) svědčí o znečištění výkaly.
Onemocnění[upravit | editovat zdroj]
Kmeny E. coli, které jsou součástí mikroflory, u zdravého jedince nevyvolávají onemocnění. Ke vzniku klinicky závažné infekce je třeba jednoho z těchto faktorů:
- narušení eumikrobie, vzniklá např. užíváním ATB nebo imunosupresí, a přemnožení E. coli;
- patogenní kmeny schopné produkce různých faktorů patogenity (toxiny, adhezivní pili);
- zavlečení infekce mimo střevo, nejčastěji do močového ústrojí, peritoneální dutiny.
Diagnostika[upravit | editovat zdroj]
Kultivace[upravit | editovat zdroj]
Kultivačně je E. coli nenáročná. K její izolaci a diagnóze se nejčastěji využívá laktózový agar. Na MacConkeyově agaru a Endově agaru roste v koloniích obklopených růžovým zbarvením, které indikuje zkvašování laktózy. Na krevním agaru roste v šedavých koloniích, některé kmeny (často patogenní) s úplnou hemolýzou.
- Escherichia coli
Biochemie[upravit | editovat zdroj]
E. coli má velmi širokou enzymatickou aktivitu, čehož se využívá při její identifikaci. Používají se tzv. barevné řady, které podle změny zbarvení po nanesení a inkubaci kolonie, umožňují přesné zařazení druhu právě podle jeho biochemických vlastností. Toho se využívá často, neboť je potřeba odlišit ostatní enterobakterie, které se účastní na střevní flóře.
Mikroskopie[upravit | editovat zdroj]
V preparátu, obarveném podle Grama, se E. coli jeví jako G− tyčinka s bičíky.
Sérologie[upravit | editovat zdroj]
Při přesnějším určování se používají klasické sérologické postupy. Toho se využívá především při sledování epidemií a šíření jednotlivých kmenů. Nejvýznamnější je nepřímá aglutinace, kterou lze odlišit jednotlivé sérotypy E. coli.
Léčba[upravit | editovat zdroj]
Běžná léčba je pouze symptomatická. Antibiotika se užívají pouze u extraintestinálních infekcí a imunosuprimovaných pacientů. Lze použít β-laktamová ATB spolu s inhibitory β-laktamáz. Escherichia coli je citlivá na většinu antibiotik.
Odkazy[upravit | editovat zdroj]
Související články[upravit | editovat zdroj]
Použitá literatura[upravit | editovat zdroj]
- HORÁČEK, Jiří, et al. Základy lékařské mikrobiologie. 1. vydání. Karolinum, 2000. ISBN 80-246-0006-4.





